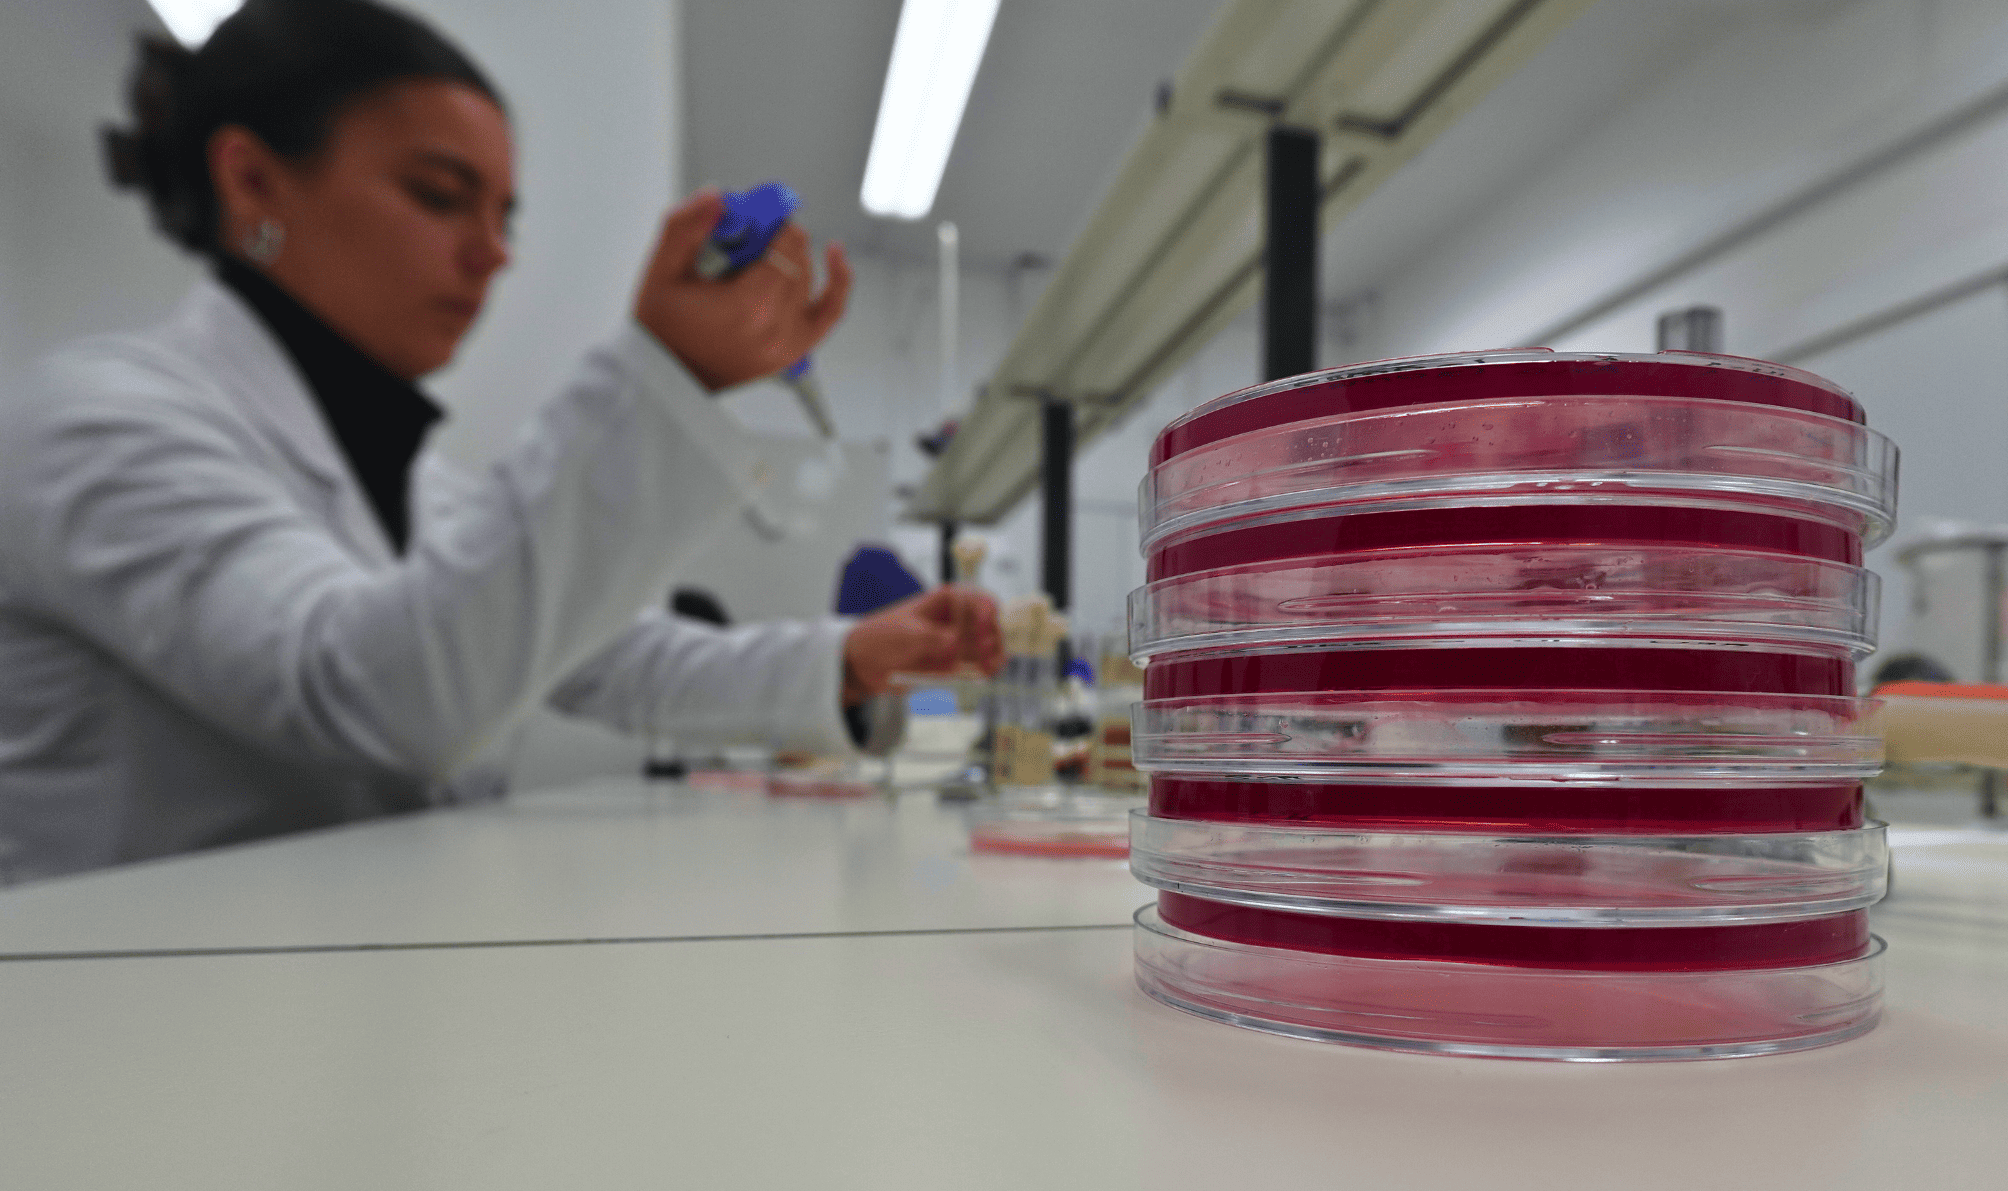

O CIVG – Centro de Investigação Vasco da Gama, unidade de de Investigação e Desenvolvimento (I&D) da EUVG, dedica-se à investigação e inovação no âmbito do conceito One Health, desenvolvendo a sua atividade de forma multidisciplinar nas áreas de Ciências Veterinárias, Ciências Biológicas e Ecossistemas.
Criado em 2017, o CIVG conta com cerca de 30 investigadores doutorados integrados e 50 colaboradores, tendo sido recentemente classificado como “Bom” pela FCT na Avaliação das Unidades de I&D 2023-2024, consolidando a sua relevância científica a nível nacional e internacional.
ORGANIZAÇÂO
Conheça os
INVESTIGADORES
bolsas de apoio à investigação
+80
Investigadores
+500
Artigos Publicados
Classificação da Fundação para a Ciência e Tecnologia
I&D
Investigação e
Desenvolvimento
Os Nossos Projetos
Abra cada projeto para descobrir mais

BioimpACE+
CARDIOSTEM

OLIVEμALGAE

Epilepsia Canina

RABBIT-EC

EDPFC1
VECTORCAT
PUPS-CHASE
MEPR1
WildPath
PlastiTox® PT
ABBa
PARA2
EPAPRU3
VetOncProtOmics
NanoMasTherapy
Atividades de Promoção da Investigação e
Conhecimento - Extensão À Comunidade
1. Encontro Anual do CIVG
Iniciativa científica estruturante do CIVG, organizada anualmente, que se centra nas principais temáticas de investigação desenvolvidas no Centro, no âmbito do conceito One Health. Este encontro visa promover a partilha de conhecimento, reforçar a ligação com parceiros externos e afirmar-se como uma referência na área da investigação interdisciplinar em saúde humana, animal e ambiental. Dirige-se à comunidade científica, académica, profissional e ao público em geral, promovendo o diálogo e a colaboração entre diferentes setores da sociedade.
2. Mini Talks do CIVG
Sessões de divulgação científica que promovem a apresentação de trabalhos desenvolvidos, resultados alcançados e novas ideias no âmbito da investigação do CIVG. Destinam-se a investigadores, docentes e alunos, funcionando como um espaço privilegiado para fomentar a partilha de conhecimento, estimular o debate e promover sinergias entre membros do CIVG e da comunidade científica envolvente. Estas sessões contribuem para a valorização da investigação e para o reforço da cultura científica institucional.
3. Haja Saúde com o CIVG
Conjunto de atividades interativas e educativas que promovem a saúde humana, animal e ambiental, aproximando a ciência da sociedade.
3.1. Ciência Viva no Verão
3.1.1. Haja Saúde na Bioreserva
Visitas interativas em áreas protegidas geridas pela MILVOZ, onde se explora a biodiversidade autóctone e os ecossistemas naturais. Estas ações convidam à descoberta da natureza e à sensibilização para a sua proteção, promovendo uma ligação entre saúde e conservação ambiental, numa perspetiva One Health.
3.1.2. Haja Saúde na Praia
Visita à zona entremarés da Praia de Buarcos para conhecer os seus habitantes marinhos e compreender a sua importância para a biodiversidade e o equilíbrio ambiental. A iniciativa destaca as principais ameaças a estes ecossistemas, como a poluição e as alterações climáticas, e apresenta os mamíferos marinhos como indicadores da saúde dos oceanos. Inclui um momento interativo sobre o que fazer em caso de avistamento de animais arrojados, como golfinhos ou focas.
3.1.3. Haja Saúde na Ilha
Caminhada na Ilha da Morraceira, um ecossistema rico em biodiversidade e moldado por atividades humanas sustentáveis como a aquacultura e a produção tradicional de sal. A iniciativa permite conhecer de perto a importância ecológica da ilha, sensibilizando para a preservação dos habitats naturais e para a ligação entre saúde, ambiente e atividade humana.
3.1.4. Haja Saúde no Parque
Peddy paper em equipa, pensado para famílias, amigos ou grupos espontâneos, com desafios e perguntas sobre saúde marinha, alterações climáticas e biodiversidade. Uma atividade divertida e educativa que promove o conhecimento científico de forma acessível e participativa.
3.1.5. Haja Saúde na Rua
Versão urbana do peddy paper, realizada nas ruas da Cidade, com foco na saúde dos oceanos, fenómenos climáticos e curiosidades locais. Uma atividade interativa que convida à descoberta científica em ambiente informal.
3.1.6. Haja Saúde na Escola
Peddy paper científico realizado em contexto escolar. Através de jogos e desafios, promove-se a literacia científica e a ligação entre ciência, saúde e ambiente.
3.2. Noite Europeia dos Investigadores
3.2.1. MITO OU VERDADE? A Farmacologia dos Nossos Animais
Quiz interativo que desafia os participantes a distinguir mitos de factos sobre o uso de medicamentos em animais de companhia, promovendo literacia em farmacologia veterinária.
3.2.2. Leite sem Lactose: A Magia da Lactose Imobilizada
Experiência prática onde os participantes transformam leite comum em leite sem lactose, explorando o papel das enzimas e da biotecnologia na alimentação inclusiva.
3.2.3. Da Genética à Função: Simulando a Síntese Proteica
Atividade prática que permite construir um modelo da síntese proteica, explicando como o corpo transforma a informação genética em proteínas.
3.2.4. Microrganismos: Heróis Escondidos ou Inimigos Silenciosos?
Observação de microrganismos reais, incluindo microbiota oral, para descobrir o papel essencial destes seres invisíveis na saúde e no equilíbrio dos ecossistemas.
3.2.5. “Temos pena mas não é comida!”
Atividade didática sobre o impacto dos microplásticos nos ecossistemas marinhos e nas cadeias alimentares.
4. Estágios de Verão CIVG
Estágios científicos para estudantes, integrados no programa Ciência Viva no Verão, que proporcionam experiências práticas em investigação no contexto One Health.
4.1. Caçadores de Insetos
Estágio em parasitologia, com trabalho de campo e laboratório sobre insetos vetores de doenças, diagnóstico morfológico e avaliação de risco de transmissão.
4.2. Exploradores do Oceano
Estágio em ecossistemas marinhos e investigação biomédica com o peixe-zebra, incluindo estudos de comportamento, bem-estar animal e ecotoxicologia.
